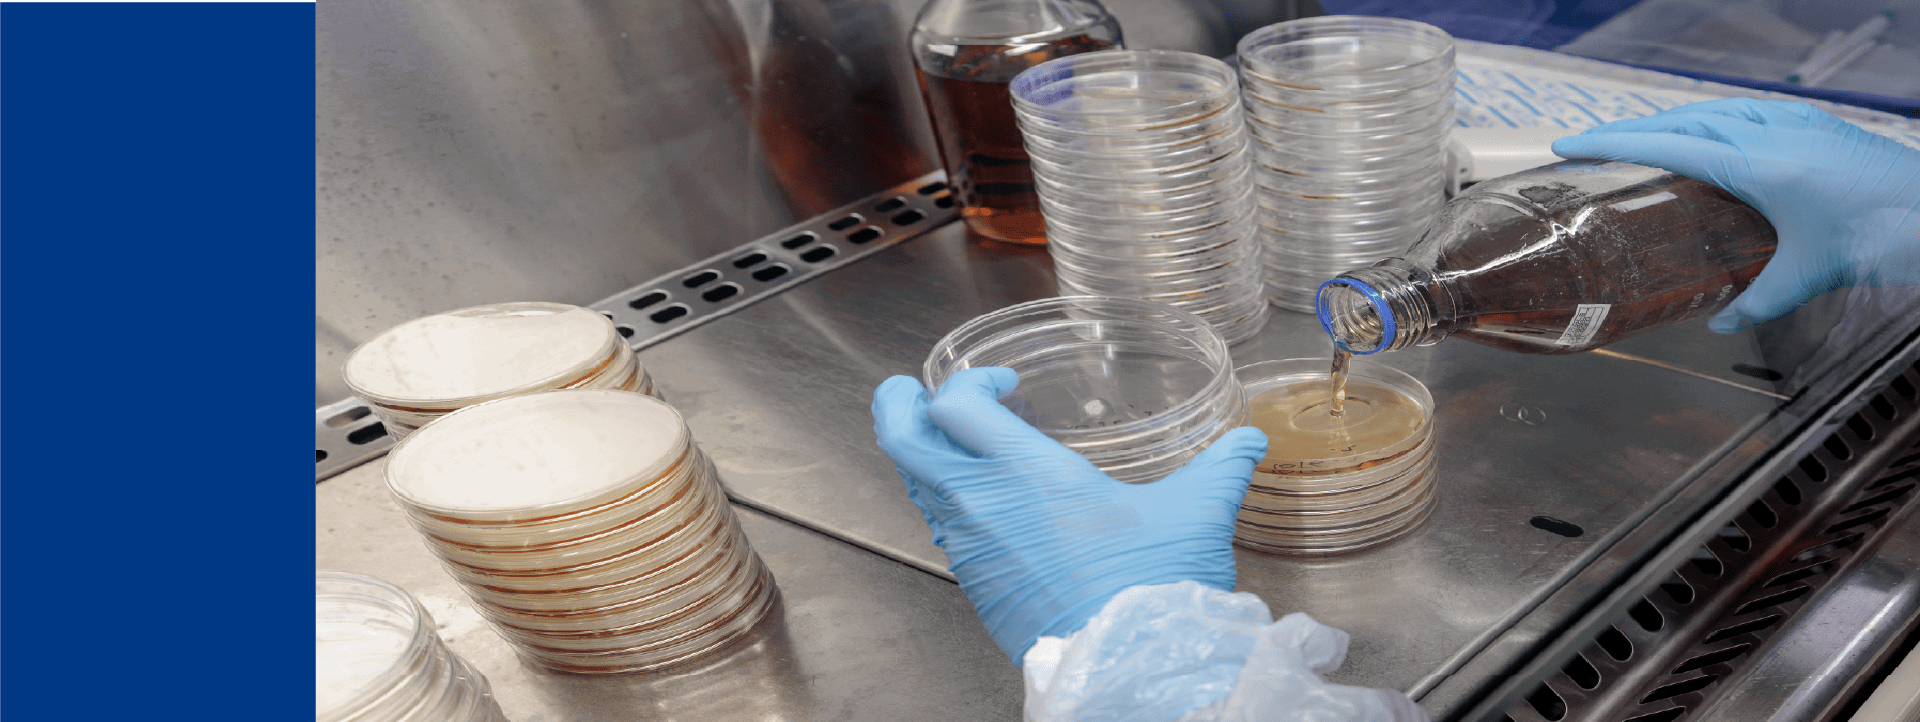
Manipulation de boîtes de Petri dans une enceinte de sécurité par un technicien de laboratoire Eurofins Biopharma Product Testing. L’image montre des gants de protection versant un liquide nutritif dans des boîtes de Petri empilées, avec des flacons de réactifs et un environnement stérile adapté aux analyses microbiologiques.

Garantir la sécurité, la durée de conservation et la conformité
Des conservateurs antimicrobiens sont ajoutés aux produits afin de prévenir ou de limiter la contamination microbienne pouvant survenir dans des conditions normales de stockage et d'utilisation. Leur efficacité peut être compromise par la formulation, le contenant ou même le principe actif pharmaceutique lui-même. Cette complexité présente un risque, non seulement pour la sécurité des patients, mais aussi pour la conformité aux réglementations mondiales strictes.
Le réseau de laboratoires Eurofins BioPharma Product Testing est en mesure de répondre à vos besoins réglementaires et techniques en matière de tests d'efficacité des conservateurs (PET). Vous pouvez compter sur des tests réalisés dans des laboratoires de microbiologie certifiés ISO, un monitoring environnemental rigoureux pour éliminer tout risque de contamination, des technologies de pointe et des microbiologistes experts qui se tiennent informés des dernières évolutions des directives pharmacopées.
Nous proposons des tests d'efficacité des conservateurs entièrement conformes pour évaluer la conservation antimicrobienne des produits pharmaceutiques :
- États-Unis : Adapté du chapitre <51> de l'USP, les études de provocation microbienne ne sont pas des études officielles
- Europe : Test d'efficacité des conservateurs – Pharmacopée Européenne 5.1.3
- Royaume-Uni : Directives actuelles de la Pharmacopée Britannique (BP), annexe XVIC, Efficacité des conservateurs antimicrobiens
Nos experts en microbiologie comprennent le comportement nuancé des agents antimicrobiens dans les produits complexes, par exemple les poudres lyophilisées qui sont reconstituées avec un diluant ou des mélanges de produits liquides. Nous concevons des études de provocation robustes qui évaluent l'efficacité antimicrobienne au fil du temps, dans des conditions de stockage et d'utilisation spécifiques.
Lors d'une étude de provocation microbienne, une faible quantité de micro-organismes est inoculée dans le produit afin de simuler une contamination lors de la préparation de la dose destinée à un patient. Les micro-organismes utilisés pour la provocation doivent inclure l'ensemble des micro-organismes mentionnés dans les lignes directrices ci-dessus, ainsi que la microflore cutanée typique et les organismes nosocomiaux. Tout au long de l'étude, le produit inoculé est retiré des conditions de stockage spécifiées et mis en culture afin de déterminer le nombre de micro-organismes présents à ce moment-là. À la fin de l'étude, le potentiel de croissance microbienne du produit est défini comme ne dépassant pas une augmentation de 0,5 log10 par rapport à la concentration de contrôle de l'inoculum.
Les études de résistance microbienne peuvent fournir des informations cruciales sur la durée de conservation des médicaments avant que la sécurité des patients ne soit compromise. Ces études évaluent l'efficacité des conservateurs et/ou des ingrédients conservateurs, les conditions de stockage optimales et, en fin de compte, la capacité de la formulation du médicament à résister à une contamination de faible niveau. Si des micro-organismes peuvent se développer dans le médicament final pendant la période de conservation, la durée de conservation prévue, la formulation du produit ou les conditions de stockage doivent être réévaluées. Eurofins BPT peut alors aider votre équipe à réévaluer et à optimiser ces paramètres grâce à des tests réalisés par des experts et conformes à la réglementation.